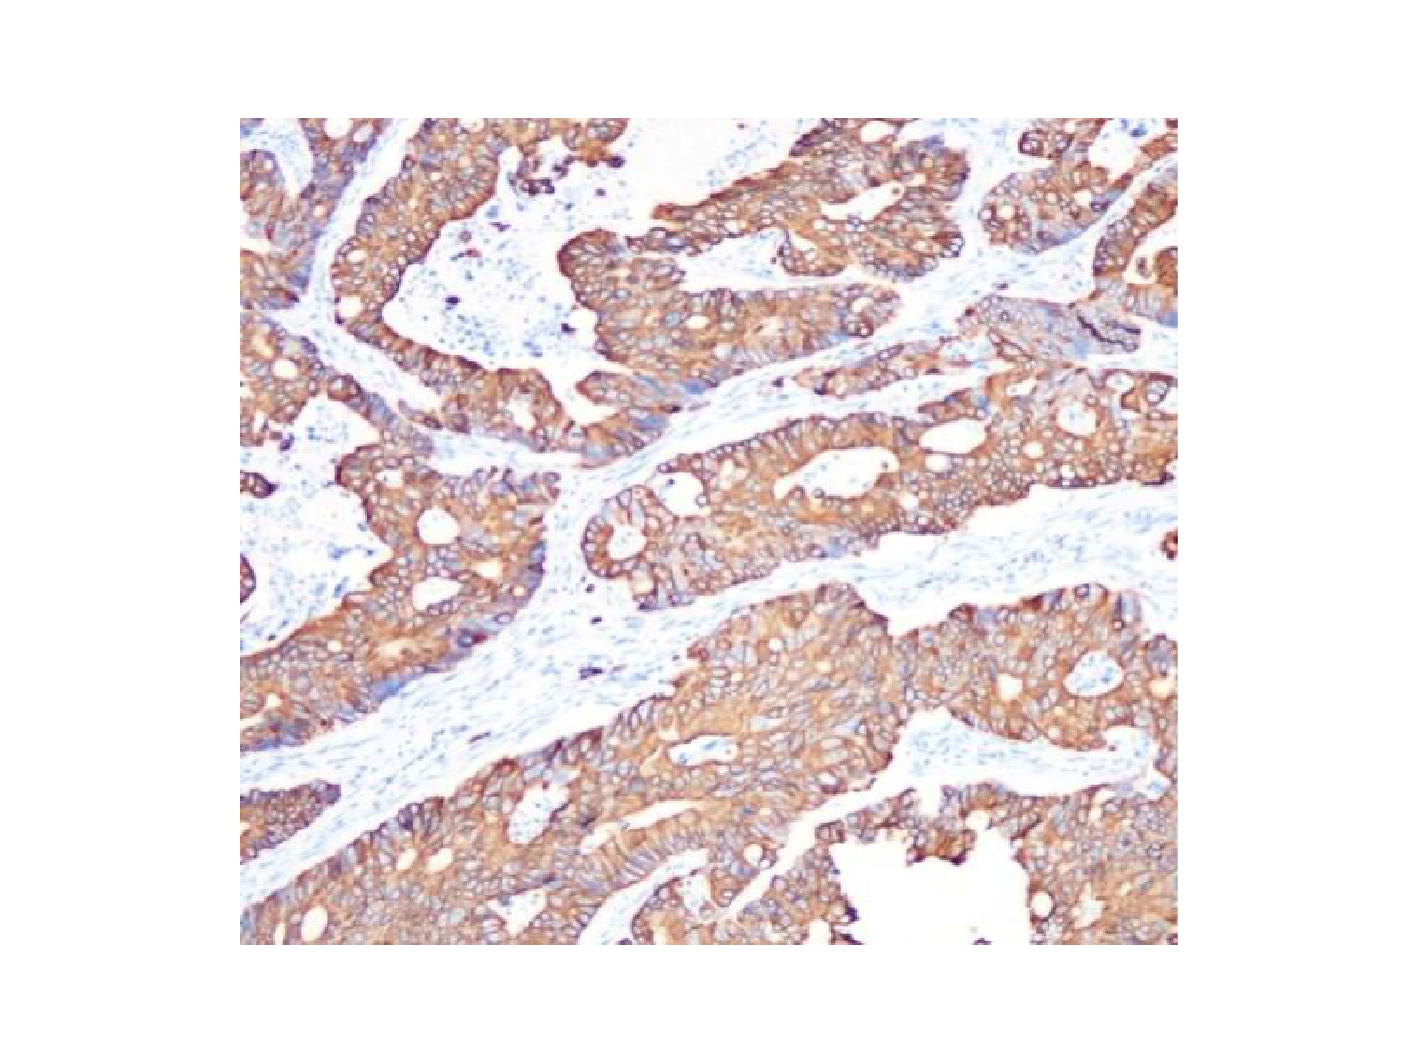

Determine the necessary mass, volume, or concentration for preparing a solution.
This is a demo store. No orders will be fulfilled.
| SKU | Size | Availability |
Price | Qty |
|---|---|---|---|---|
|
Ab098925-10μl
|
10μl |
5
|
$69.90
|
|
|
Ab098925-50μl
|
50μl |
1
|
$207.90
|
|
|
Ab098925-100μl
|
100μl |
2
|
$327.90
|
|
|
Ab098925-1ml
|
1ml |
Available within 8-12 weeks(?)
Production requires sourcing of materials. We appreciate your patience and understanding.
|
$2,397.90
|
|
Recombinant (RR648); Rabbit anti Human Cytokeratin 20 Antibody; WB, IHC, ICC, IF, Flow, IP; Unconjugated
| Product Name | Recombinant Cytokeratin 20 Antibody - Primary antibody, specific to Cytokeratin 20, Rabbit IgG |
|---|---|
| Synonyms | CD20 antibody | CK 20 antibody | CK-20 antibody | CK20 antibody | Cytokeratin-20 antibody | Cytokeratin20 antibody | K1C20_HUMAN antibody | K20 antibody | KA20 antibody | Keratin 20 antibody | keratin 20, type I antibody | keratin 21, rat, homolog of anti |
| Specifications & Purity | ExactAb™, Validated, Recombinant, High performance, 0.5 mg/mL |
| Host species | Rabbit |
| Specificity | Cytokeratin 20 |
| Immunogen | A synthetic peptide corresponding to residues on the C-terminus of human Cytokeratin 20. |
| Positive Control | WB: HT-29 cell lysate. IHC: Colonic adenocarcinoma tissue. Flow: HT-29 cells. ICC/IF: HT-29 cells. IP: HT-29 whole cell lysate. |
| Conjugation | Unconjugated |
| Grade | ExactAb™, High Performance, Recombinant, Validated |
| Product Description |
Rabbit anti Human Cytokeratin 20 Antibody, Recombinant antibody (RR648), could be used for WB, IHC, ICC/IF, Flow and IP. |
| Isotype | Rabbit IgG |
|---|---|
| SDS-PAGE | 150 kDa |
| Purification Method | Protein A purified |
| Shape | Liquid |
| Concentration | 0.5 mg/mL |
| Storage Temp | Store at -20°C,Avoid repeated freezing and thawing |
| Shipped In | Ice chest + Ice pads |
| Stability And Storage | Store at 4°C short term (1-2 weeks). Store at -20°C long term (24 months). Upon receipt, it is recommended to aliquot. Avoid freeze/thaw cycle. |
| Activity Type | Activity Value -log(M) | Mechanism of Action | Activity Reference | Publications (PubMed IDs) |
|---|

Recombinant ACTA2 Antibody (Ab088446) - Western Blot
All lanes: Recombinant Cytokeratin 20 Antibody (Ab098925) at 1/1000 dilution
Samples: Lysates at 20 µg per lane
Secondary: Goat Anti-Rabbit IgG H&L (HRP) (Ab170144) at 1/20000 dilution
Predicted band size: 49 kDa
Observed band size: 46 kDa
Exposure time: 0.1 s

Recombinant Cytokeratin 20 Antibody (Ab098925) - IF/ICC
Recombinant Cytokeratin 20 Antibody (Ab098925) staining Cytokeratin 20 in HT-29 cells by IF/ICC (Immunocytochemistry/immunofluorescence). Cells were fixed with paraformaldehyde, permeabilized with 0.1% Triton X-100 and blocked with 10% goat serum for half an hour at room temperature. Samples were incubated with Recombinant Cytokeratin 20 Antibody (Ab098925) (1/200) at 4°C. An AF488-conjugated Goat Anti-Rabbit IgG polyclonal was used as the secondary antibody (1/500).

Recombinant Cytokeratin 20 Antibody (Ab098925) - Flow Cytometry
Overlay histogram showing HT-29 cells stained with Recombinant Cytokeratin 20 Antibody (Ab098925) (Red). The cells were fixed with 4% paraformaldehyde (10 min) and then permeabilized with 0.1% TritonX-100 for 15 min. The cells were then incubated in Recombinant Cytokeratin 20 Antibody (Ab098925) (1/1000 dilution) in 1x PBS/1% BSA for 30 min at 4°C. The secondary antibody used was a Goat Anti-Rabbit AF488 (IgG H+L) at 1/2000 dilution for 20 min at 4°C. Unlabeled sample (Blue) was used as a control.
Recombinant Cytokeratin 20 Antibody (Ab098925) - IHC
Immunohistochemistry (Formalin/PFA-fixed paraffin-embedded sections) analysis of colonic adenocarcinoma tissue labelling Cytokeratin 20 with Recombinant Cytokeratin 20 Antibody (Ab098925) at 1/800. Heat mediated antigen retrieval was performed using Tris/EDTA buffer pH 9.0.

Recombinant Cytokeratin 20 Antibody (Ab098925) - IP
Cytokeratin 20 was immunoprecipitated from 0.5 mg of HT-29 lysate with Recombinant Cytokeratin 20 Antibody (Ab098925) at 1/50 dilution.
2nd Ab: G&R HRP for IP 1/500
Lane 1: Recombinant Cytokeratin 20 Antibody (Ab098925) IP in HT-29 whole cell lysate
Lane 2: PBS instead of Recombinant Cytokeratin 20 Antibody (Ab098925) in HT-29 whole cell lysate
Lane 3: HT-29 whole cell lysate, 10 μg (input)
Exposure: 30.0 s.
| Application | Dilution info |
|---|---|
| IP |
1/50
|
| WB |
1/5000 - 1/20000
|
| IHC | 1/800 - 1/1600 |
| Flow Cytometry |
1/10-1/1000
|
| IF/ICC |
1/50-1/2000
|
Find and download the COA for your product by matching the lot number on the packaging.
| Lot Number | Certificate Type | Date | Item |
|---|---|---|---|
| Certificate of Analysis | Oct 10, 2023 | Ab098925 | |
| Certificate of Analysis | Oct 10, 2023 | Ab098925 |

Starting at $79.90

Starting at $79.90

Starting at $79.90